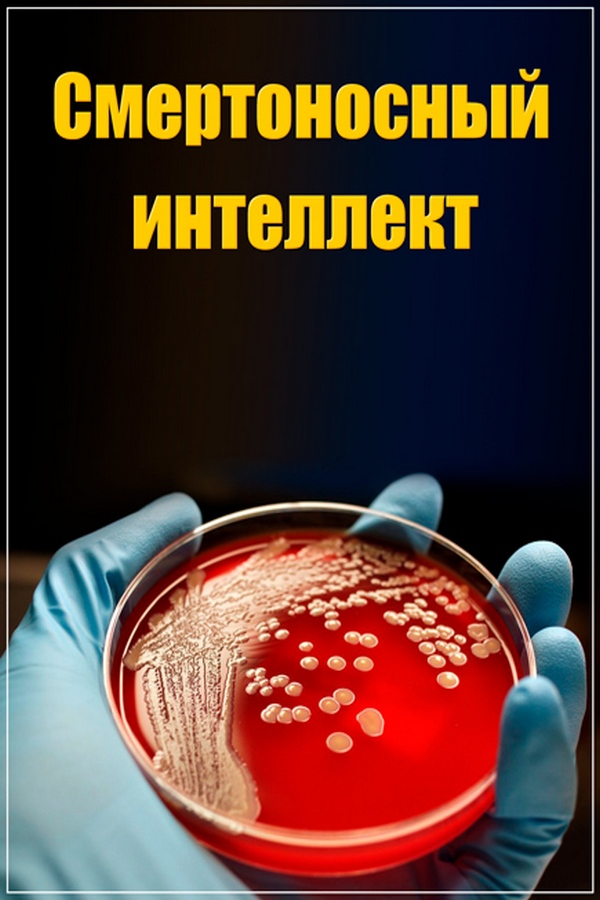

Смертоносный интеллект (2018)
Напоминание о выходе документального сериала «Смертоносный интеллект»
Сейчас нет запланированных эфиров этой программы.
Хотите получить уведомление, когда она вновь появится в сетке вещания?
Жанры: История, Криминал
Страны производства: Великобритания, США
Темы: Безопасность, Тайна, Убийство
Категория: Документальный сериал
Год выпуска: 2018
Возрастной рейтинг: 12+ (зрителям, достигшим 12 лет)
Доступна перемотка (Catch-up): Да
Продолжительность: 50 мин.
Эпизоды документального сериала «Смертоносный интеллект»
| ID эпизода | Сезон | Серия | Название эпизода | Описание |
|---|---|---|---|---|
| 1462740 | 1 | 1 | Брюс Айвинс | Всего через несколько дней после смерти армейского учёного доктора Брюса Айвинса, ФБР называет его имя в качестве распространителя сибирской язвы. Но многие до сих пор оспаривают его виновность |
| 1469196 | 1 | 2 | Фрэнк Олсон | Когда ученый из ЦРУ Фрэнк Олсон прыгает из окна отеля на Манхэттене, его смерть становится началом одной из самых интригующих загадок в истории Америки. Возможно ли, что ЦРУ заставило его замолчать? |
| 1476295 | 1 | 3 | Дон Вайли - Хайнц Круг | Вирусолог доктор Дон Вайли покидает отель в Мемфисе и больше его никто не видит. Суицид, убийство или исследования Вайли сделали его целью био-террориста? |
| 1485766 | 1 | 5 | Джек Парсонс | Летом 1952 года в импровизированное лаборатории в Пасадене прогремел взрыв, убивший американского пионера ракетостроения Джека Парсонса. Было ли это убийство, несчастный случай или суицид? |
| 1349610 | 1 | 6 | 6-я серия | |
| 1349553 | 1 | 7 | Шейн Тодд и Яхья Эль-Машад | Инженер доктор Шейн Тодд найден мертвым в Сингапуре, а Яхья Эль-Машад убит в отеле в Париже. Может ли смерть Эль-Машада быть связанной с его работой на Саддама Хуссейна? |
Будущие показы
В ближайшее время по ТВ показов не запланировано.
Прошедшие показы
Загрузка.
Загрузка.
Загрузка.
Загрузка.
Загрузка.
Загрузка.
Загрузка.
Загрузка.
Загрузка.
Загрузка.
Загрузка.
Нет прошедших показов.
Загрузка.
Загрузка.
Загрузка.
Загрузка.
Загрузка.